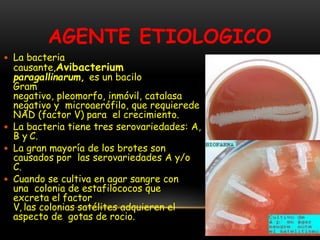
AGENTE ETIOLOGICO
 La bacteria
causante,Avibacterium
paragallinarum, es un bacilo
Gram
negativo, pleomorfo, inmóvil, catalasa
negativo y microaerófilo, que requierede
NAD (factor V) para el crecimiento.
 La bacteria tiene tres serovariedades: A,
B y C.
 La gran mayoría de los brotes son
causados por las serovariedades A y/o
C.
 Cuando se cultiva en agar sangre con
una colonia de estafilococos que
excreta el factor
V, las colonias satélites adquieren el
aspecto de gotas de rocio.

La coriza infecciosa es una enfermedad respiratoria bacteriana de las aves causada por Avibacterium paragallinarum. Provoca síntomas como estornudos, exudado nasal y disminución de la producción de huevos. Se transmite directamente de ave enferma a sana o indirectamente a través de bebederos y comederos contaminados. El tratamiento incluye el uso de antibióticos como tetraciclinas aunque no puede eliminar la enfermedad completamente. La prevención mediante separación de aves, compra de av